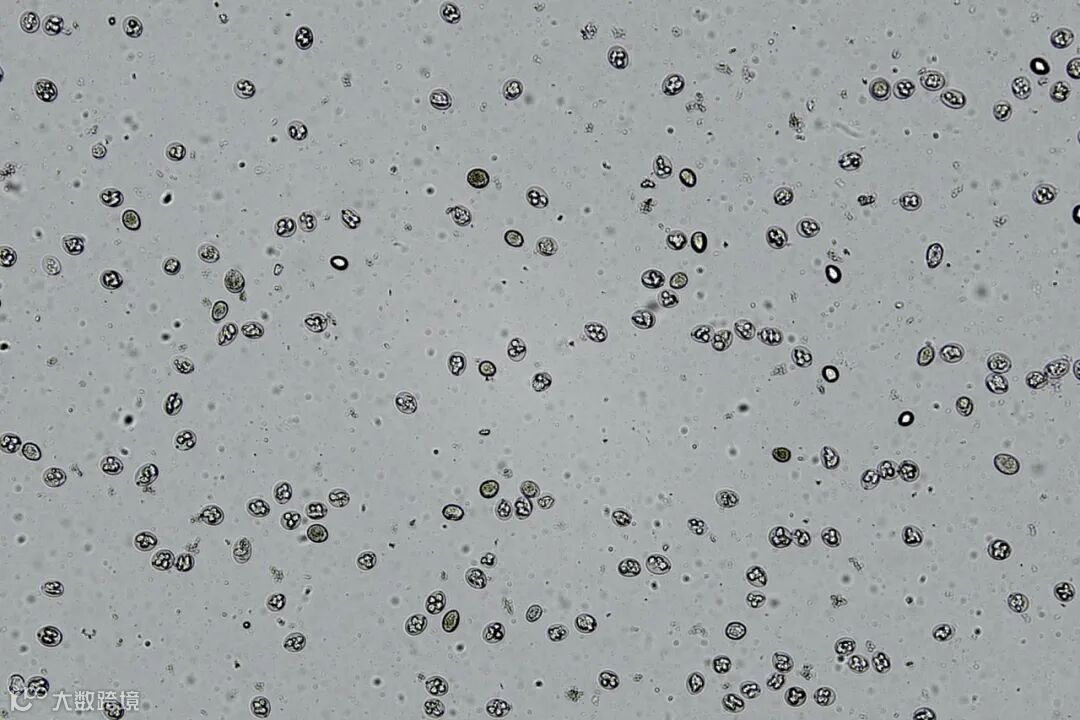

寄生虫卵囊是寄生虫在宿主体内繁殖的产物,数量和分布情况可以反映感染的程度和病情的严重程度。通过卵囊计数,可以了解感染者的感染状况,为制定针对性的预防和治疗措施提供依据;还可以用于监测和控制寄生虫病的流行,为制定有效的防控措施提供科学依据。

因此,寄生虫卵囊计数是寄生虫病防治工作中不可或缺的重要手段之一,实验室常见的检测方法包括直接涂片法、漂浮法和沉淀法等。
1. 直接涂片法:用载玻片滴一滴清水,用灭活后的针头挑取虫卵,将虫卵放入水中,然后在高倍显微镜下观察计数,这种方法适用于多种寄生虫卵囊的计数。
2. 漂浮法:这种方法主要是通过毛细作用,将液滴表面的卵囊和部分悬浮液的卵囊推入计数池进行观察、计数。这种方法适用于体积较大或密度较大的寄生虫卵囊。
3. 沉淀法:这种方法适用于沉淀较好的寄生虫感染,将粪便与虫卵沉淀物搅匀,将浮在上面的卵囊除去,再将底部的沉淀物放到计数池进行计数,这种方法适用于密度较低的寄生虫感染。
以上方法普遍存在操作难度大和耗时长的问题,寄生虫卵囊和虫卵的形态和大小各异,计数过程中需要仔细辨认和分类,对操作人员的专业知识和技能要求较高,而且需要耗费大量的人力、物力和时间,尤其对于刚进实验室的新手,还存在主观性强,准确性不能保证的问题。
萌薇生物针对传统人工卵囊计数方法的痛点,采用高清的成像平台,并应用先进的深度学习人工智能算法,开发出一款针对寄生虫卵囊自动识别和计数的SmartCell 900 BF,这不仅大大提高了寄生虫卵囊计数的检测效率,避免主观判断,影响准确性;而且检测数据可追溯,自带审计追踪功能,尤其是临床检测更有保障。
SmartCell 900 BF
球虫、隐孢子虫
等寄生虫卵囊计数
酵母、小球藻计数
人工智能算法
630万像素高清成像
6样品孔通量
10倍光学放大
定制化算法识别学习
客户应用案例
1
鸡球虫卵囊计数
球虫是一种单细胞的宿主特异性的寄生虫,其卵囊被一个厚的外壳包裹,由一个单细胞构成,对外界环境具有非常强的抵抗力。卵囊通过孢子化达到感染性阶段,感染性的卵囊具有4个孢子囊,每个孢子囊含有2个子孢子。

鸡球虫分布广泛、有养鸡的地方就有鸡球虫,球虫病造成全球损失超过35亿英镑/年,中国损失超过35亿人民币/年。该病暴发时致死率可达50%以上,严重影响鸡的生产性能。鸡场通常会通过粪检来判断是否感染球虫以及感染的程度,却时常面临着检测样本多,耗时长、效率低等问题。
萌薇SmartCell 900通过人工智能AI算法学习,不仅能够准确识别球虫卵囊,还可以精确区分孢子化和未孢子化卵囊。球虫卵囊的准确计数将对球虫病的诊断提供重要参考意义。

明场原图

识别图
鸡球虫计数分析(SmartCell 900摄)
明场原图

识别图
鸡球虫孢子化分析(SmartCell 900摄)
2
隐孢子虫卵囊计数
隐孢子虫为体积微小的球虫类寄生虫,其生活史有滋养体、裂殖体、配子体、合子和卵囊5个发育阶段,其中卵囊是感染阶段,卵囊直径为4-6μm,囊壁光滑、无色。
隐孢子虫卵囊的计数,目前主要利用血球计数板在显微镜观察计数,该方法容易造成污染传播,使用萌薇SmartCell 900,并采用一次性耗材,不仅有效降低样本传播风险,还能够缩短计数时间和提高计数的稳定性和准确性,以及数据的可追溯性。

明场原图

识别图
隐孢子虫卵囊计数分析(SmartCell 900摄)
3
滴虫计数
滴虫属于毛滴虫目毛滴虫科,是一种寄生于阴道的致病性厌氧原虫。滴虫体型极小,在显微镜下观察呈卵圆梨形或瓜子性,其直径约为4-8μm,透明度高。
通过监测粪便或阴道分泌物中的滴虫数量,可以了解感染者受到感染的程度,以及治疗是否有效,滴虫计数的结果还可能用于指导临床治疗方案的制定。因此,滴虫计数是一种有用的辅助诊断和治疗效果监测的手段。

明场原图

识别图
滴虫计数分析(SmartCell 900摄)

对于寄生虫病的治疗和防控,卵囊计数可以提供重要的参考信息;其次卵囊计数也是评估环境卫生和健康风险的重要手段。通过监测环境中的寄生虫卵囊,可以了解周围环境中的污染程度和传播途径;再者还可以为科研和流行病学调查提供数据支持。
萌薇SmartCell 900 BF利用AI智能算法,针对不同种属的寄生虫卵囊可进行定制化学习,该产品的开发将为寄生虫卵囊计数提供新思路,不仅提高卵囊计数的准确性和效率,缩短检测时间,为寄生虫病的诊断、治疗监测和流行病学调查提供更加客观和准确的依据。此外,它还可以实现批量检测,适用于大规模样本的检测和分析,为寄生虫病的防控和监测提供更加高效和便捷的手段。


关于萌薇
上海萌薇生物医疗科技有限公司总部位于上海市宝山区沪太路4290号1876新视觉产业园区,在全国多个省市布局销售网络,是一家集研发、生产、销售和服务于一体的高科技公司。自2020年8月创建以来,上海萌薇生物医疗科技有限公司已经取得了ISO9001质量管理体系认证证书,国家级高新技术企业证书,成为北上海生物医药产业联盟成员,获批上海市宝山区区级企业技术中心,取得了2022年度上海市宝山区大场镇科创先锋等荣誉。作为技术驱动型的公司,萌薇期望其提供的设备可为全世界范围内的大学、医院和生物医药研究实验室提供帮助,期望客户工作因萌薇的帮助而变得越来越智能、越来越简单。萌薇自创立以来,在智能生物医疗仪器设备领域深耕细作,已有多款优质产品面世,为超过500家科研单位、医院、研究所、药厂及生物公司提供产品。萌薇感谢每一个合作伙伴和用户的信任与支持,并将不断推出新的产品和应用,为客户提供更优良的产品和服务。

END





